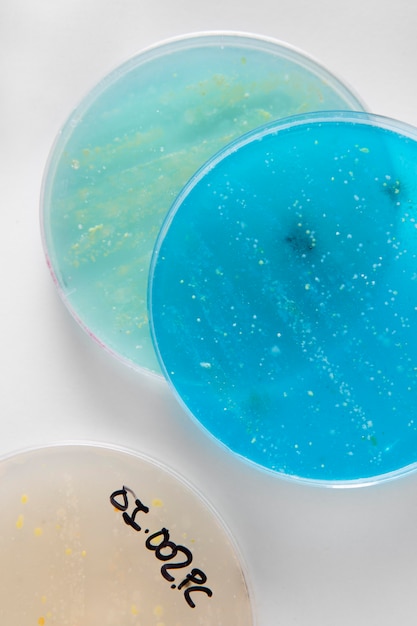

Los espectros atómicos y la absorción son conceptos fundamentales en la física y la química. Los espectros atómicos son patrones de radiación electromagnética emitidos por los átomos cuando se excitan. Estos patrones son únicos para cada elemento químico y se utilizan para identificar elementos en la materia. Por otro lado, la absorción se refiere a la capacidad de los átomos para absorber radiación electromagnética en ciertas longitudes de onda.
La comprensión de los espectros atómicos y la absorción es crucial para la investigación en diversas áreas, como la astrofísica, la química y la medicina. Por ejemplo, los científicos pueden utilizar los espectros atómicos para estudiar la composición de las estrellas y el universo en general. En la medicina, la absorción de radiación electromagnética se utiliza para la detección de enfermedades y el tratamiento del cáncer.
Los espectros atómicos y su formación
Los espectros atómicos son patrones de líneas de luz que se observan cuando se excita un átomo y luego se le permite volver a su estado fundamental. Cada elemento químico tiene un espectro atómico único que se puede utilizar para identificarlo.
Los átomos están compuestos por protones, neutrones y electrones. Los electrones pueden moverse entre diferentes niveles de energía dentro del átomo. Cuando un átomo se excita, un electrón absorbe energía y salta a un nivel de energía más alto. Luego, cuando el electrón regresa a su nivel de energía original, libera la energía absorbida en forma de luz.
La luz emitida por el átomo es lo que se conoce como espectro atómico. El espectro se compone de diferentes líneas de luz, cada una correspondiente a una transición de energía diferente en el átomo. Cada elemento químico tiene un espectro atómico único, lo que significa que se pueden identificar los elementos presentes en una muestra simplemente observando su espectro.
Existen tres tipos de espectros atómicos: espectros de emisión, espectros de absorción y espectros de emisión y absorción. Los espectros de emisión se producen cuando un átomo emite luz después de ser excitado. Los espectros de absorción se producen cuando un átomo absorbe luz y luego se emite un espectro de emisión. Los espectros de emisión y absorción se producen cuando un átomo emite y absorbe luz al mismo tiempo.
Contenidos
- Los espectros atómicos y su formación
- La relación entre los espectros atómicos y la absorción de luz
- La importancia de los espectros atómicos en la identificación de elementos químicos
- ¿Cómo se obtienen los espectros atómicos?
- ¿Por qué son importantes los espectros atómicos?
- La importancia de los espectros atómicos en la ciencia y tecnología
- Preguntas frecuentes sobre los espectros atómicos y la absorción
- Relacionados
- Las leyes de Kepler y la velocidad orbital en cuerpos celestes
- Partículas subatómicas: Comprendiendo el universo y la tecnología
- La influencia de Isaac Newton en la Revolución Científica del siglo XVII
- Velocidad de la luz vs velocidad del sonido: diferencias, ejemplos y su importancia en la tecnología...
- La velocidad de espacio: conceptos, mediciones e implicaciones en la exploración espacial
- Tipos de Reactores Nucleares: BWR, PWR y RBMK
- Tamaño y Reactividad: Descubriendo los Secretos de los Átomos
- El acelerador de partículas: pasado, presente y futuro
- Central Nuclear: Funcionamiento, Componentes y Generación de Energía
- ¿que teoria defendio isaac newton?
- Calculando el movimiento de rotación: fórmulas, ejemplos prácticos y herramientas
- La estructura del átomo: Todo lo que necesitas saber
- La Velocidad de Escape: La Clave para Salir del Sistema Solar
- Cesio 133: El reloj atómico y su impacto en la tecnología y la ciencia
- La velocidad de la luz y su impacto en la física moderna
- Explorando el universo: aceleradores de partículas, el LHC y la materia oscura
- La revolución científica de Newton: de la ley de gravitación al cálculo y la física moderna
- El Gran Colisionador de Hadrones: El acelerador de partículas más grande y poderoso del mundo
- La carrera por la bomba más poderosa: Tsar, hidrógeno, MOAB y la búsqueda constante
- Distancia en la Física: Concepto, Unidades y Cálculo

La relación entre los espectros atómicos y la absorción de luz
La absorción de luz es un fenómeno que se produce cuando la energía de la luz es transferida a los átomos y moléculas de la materia. Cuando un átomo absorbe energía, sus electrones se excitan y saltan a un nivel de energía superior. Sin embargo, estos electrones no pueden permanecer en ese nivel de energía de forma indefinida y, por lo tanto, vuelven a su estado original emitiendo energía en forma de luz.
La luz emitida por un átomo es única y se puede identificar por su espectro atómico. El espectro atómico es una representación gráfica de las diferentes longitudes de onda de la luz que un átomo emite cuando sus electrones vuelven a su estado original.
Por otro lado, cuando la luz atraviesa un gas, algunos átomos absorben ciertas longitudes de onda de la luz, lo que resulta en una disminución en la intensidad de la luz que se transmite. Este fenómeno se conoce como absorción de luz y se puede identificar por la presencia de líneas oscuras en el espectro de la luz transmitida.
La relación entre los espectros atómicos y la absorción de luz es muy importante en la astronomía, ya que nos permite identificar los elementos químicos presentes en las estrellas y galaxias distantes. Además, también es útil en la investigación de la composición de la atmósfera terrestre y en la identificación de compuestos químicos en la industria.
La importancia de los espectros atómicos en la identificación de elementos químicos
Cuando se trata de identificar elementos químicos, los espectros atómicos son una herramienta fundamental. Estos espectros son la representación gráfica de la luz emitida o absorbida por un átomo cuando se excita. Cada elemento químico tiene su propio espectro atómico, lo que lo hace único y permite su identificación.
¿Cómo se obtienen los espectros atómicos?
Para obtener un espectro atómico, se necesita un espectrómetro. Este instrumento separa la luz en sus diferentes longitudes de onda, lo que permite identificar las líneas espectrales únicas para cada elemento químico. Estas líneas espectrales se producen cuando los electrones de un átomo se mueven de un nivel de energía a otro.
¿Por qué son importantes los espectros atómicos?
Los espectros atómicos son importantes por varias razones. En primer lugar, permiten la identificación de elementos químicos en muestras desconocidas. Si se conoce el espectro atómico de un elemento, se puede comparar con el espectro de la muestra desconocida y determinar si ese elemento está presente.
En segundo lugar, los espectros atómicos son útiles para la investigación científica. Al estudiar los espectros atómicos de diferentes elementos, los científicos pueden obtener información sobre la estructura atómica y las propiedades de los elementos. Esto es especialmente importante en la astronomía, donde los espectros atómicos se utilizan para identificar los elementos presentes en las estrellas y otros cuerpos celestes.
La importancia de los espectros atómicos en la ciencia y tecnología
Los espectros atómicos son una herramienta fundamental en la ciencia y tecnología moderna. Estos espectros son la huella dactilar de los átomos, y permiten identificar los elementos químicos que se encuentran en una muestra.
Los espectros atómicos se obtienen al excitar los átomos de una muestra, ya sea mediante calor, electricidad o radiación electromagnética. Cuando los átomos se excitan, liberan energía en forma de luz, y esta luz se descompone en diferentes colores al pasar por un prisma. Cada elemento químico produce un patrón de líneas de colores únicos en su espectro atómico, lo que permite identificarlo con precisión.
La importancia de los espectros atómicos se extiende a muchos campos de la ciencia y la tecnología. En la astronomía, por ejemplo, se utilizan para analizar la composición química de las estrellas y galaxias. En la medicina, se utilizan para identificar elementos tóxicos en el cuerpo humano. En la industria, se utilizan para controlar la calidad de los productos químicos.
Además, los espectros atómicos han sido fundamentales para el desarrollo de la física cuántica. El hecho de que cada elemento químico tenga un patrón de líneas de colores único en su espectro atómico, llevó a la conclusión de que los átomos sólo pueden tener ciertos niveles de energía, y que la energía se libera en forma de luz cuando los átomos cambian de un nivel de energía a otro.
Preguntas frecuentes sobre los espectros atómicos y la absorción
Los espectros atómicos y la absorción son conceptos clave en la física y la química moderna. Aunque pueden parecer complejos a primera vista, son esenciales para entender cómo funcionan los átomos y las moléculas. En esta sección de preguntas frecuentes, responderemos a algunas de las dudas más comunes sobre estos temas. Si eres estudiante de ciencias o simplemente tienes curiosidad por saber más sobre el mundo que nos rodea, ¡sigue leyendo!
¿Cómo se relacionan los espectros de absorción y emisión con la estructura electrónica de los átomos y moléculas, y cómo se pueden utilizar para determinar la composición química y las propiedades físicas de las sustancias?
Los espectros de absorción y emisión están relacionados con la estructura electrónica de los átomos y moléculas. La absorción ocurre cuando un electrón salta a un nivel de energía más alto y la emisión ocurre cuando un electrón cae a un nivel de energía más bajo. Estos espectros se pueden utilizar para determinar la composición química y las propiedades físicas de las sustancias mediante la identificación de las líneas de absorción y emisión específicas para cada elemento o compuesto.
¿Qué son los espectros atómicos y de absorción y cómo se relacionan con la estructura de los átomos y moléculas?
Los espectros atómicos y de absorción son patrones de radiación electromagnética que emiten o absorben los átomos y moléculas. Estos patrones están relacionados con la estructura de los átomos y moléculas, ya que cada uno tiene un conjunto único de niveles de energía. Cuando un átomo o molécula absorbe o emite radiación, lo hace en una frecuencia específica que corresponde a la diferencia de energía entre dos niveles de energía. Los espectros de absorción se utilizan para identificar las sustancias presentes en una muestra, mientras que los espectros atómicos se utilizan para determinar la composición de una muestra.
